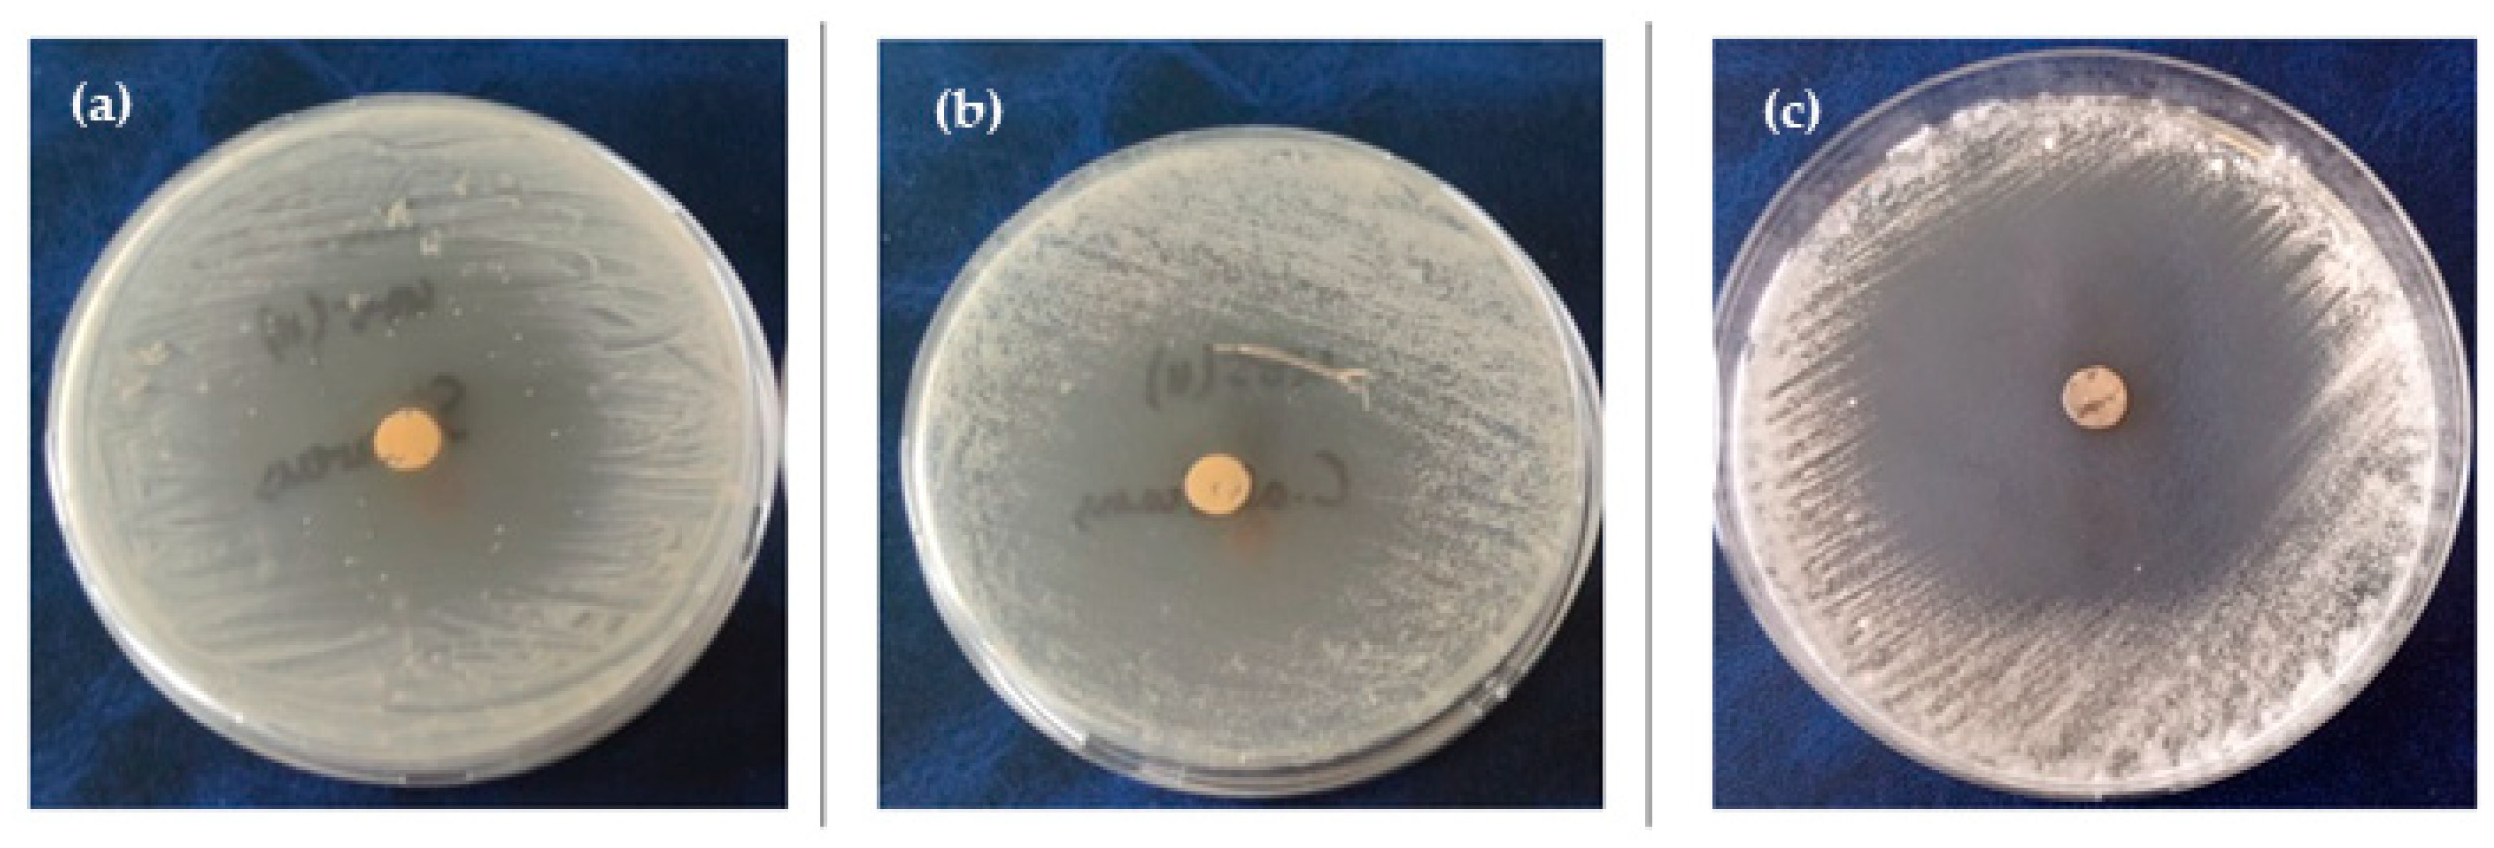
Coatings 15 01327 g006 Coatings 15 01327 g006

Can Satureja montana Essential Oil Promote Edible Films Based on Plum Oil Cake into Antimicrobial and Antioxidant Food Packaging?
Abstract
1. Introduction
2. Materials and Methods
2.1. Materials
2.2. Plum Oil Cake-Based Films Synthesis
- C—control sample, plum oil cake-based film without essential oil addition.
- 1% SMeo—plum oil cake-based film with 1% (v/v) Satureja montana essential oil addition.
- 2% SMeo—plum oil cake-based film with 2% (v/v) Satureja montana essential oil addition.
- 3% SMeo—plum oil cake-based film with 3% (v/v) Satureja montana essential oil addition.
2.3. Plum Oil Cake-Based Films Characterization
2.3.1. Mechanical Properties
2.3.2. Physico-Chemical Properties
2.3.3. Water Barrier Properties
2.3.4. Structural Properties—Fourier-Transform Infrared Spectroscopy (FTIR)
2.3.5. Antioxidative Activity—DPPH Assay
2.3.6. Thermal Analysis—Differential Scanning Calorimetry (DSC)
2.3.7. Antimicrobial Properties—Disc Diffusion Assay
2.3.8. Statistical Analysis
3. Results and Discussion
3.1. Mechanical Properties
3.2. Physico-Chemical Properties of Biofilms
3.3. Water Barrier Properties
3.4. Structural Properties—Fourier-Transform Infrared Spectroscopy (FTIR)
3.5. Thermal Analysis—Differential Scanning Calorimetry (DSC)
3.6. Microbial Activity—Disc Diffusion Assay
3.7. Antioxidative Activity—DPPH Assay
3.8. Standard Score Analysis
4. Conclusions
Author Contributions
Funding
Institutional Review Board Statement
Informed Consent Statement
Data Availability Statement
Acknowledgments
Conflicts of Interest
References
- Industry Agenda, World Economic Forum. The New Plastics Economy: Rethinking the Future of Plastics. 2016. Available online: http://www3.weforum.org/docs/WEF_The_New_Plastics_Economy.pdf (accessed on 15 August 2025).
- Ncube, L.K.; Ude, A.U.; Ogunmuyiwa, E.N.; Zulkifli, R.; Beas, I.N. Environmental Impact of Food Packaging Materials: A Review of Contemporary Development from Conventional Plastics to Polylactic Acid Based Materials. Materials 2020, 13, 4994. [Google Scholar] [CrossRef]
- Galus, S.; Kibar, E.A.A.; Gniewosz, M.; Krasniewska, K. Novel materials in the preparation of edible films and coatings—A review. Coatings 2020, 10, 674. [Google Scholar] [CrossRef]
- Oluba, O.M.; Obi, C.F.; Akpor, O.B.; Ojeaburu, S.I.; Ogunrotimi, F.D.; Adediran, A.A.; Oki, M. Fabrication and characterization of keratin starch biocomposite film from chicken feather waste and ginger starch. Sci. Rep. 2021, 11, 8768. [Google Scholar] [CrossRef] [PubMed]
- Dhumal, C.V.; Sarkar, P. Composite edible films and coatings from food-grade biopolymers. J. Food Sci. Technol. 2018, 55, 4369–4383. [Google Scholar] [CrossRef]
- Mujtaba, M.; Fernandes Fraceto, L.; Fazeli, M.; Mukherjee, S.; Savassa, S.M.; de Medeiros, G.A.; do Espírito Santo Pereira, A.; Donnini Mancini, S.; Lipponen, J.; Vilaplana, F. Lignocellulosic biomass from agricultural waste to the circular economy: A review with focus on biofuels, biocomposites and bioplastics. J. Clean. Prod. 2023, 402, 136815. [Google Scholar] [CrossRef]
- Marotta, A.; Borriello, A.; Khan, M.R.; Cavella, S.; Ambrogi, V.; Torrieri, E. Boosting Food Packaging Sustainability Through the Valorization of Agri-Food Waste and By-Products. Polymers 2025, 17, 735. [Google Scholar] [CrossRef] [PubMed]
- Gonalves, J.; Anjos, O.; Guin, R. A Revisit of Plant Food Waste Along Food Supply Chains: Impacts and Perspectives. Foods 2025, 14, 1364. [Google Scholar] [CrossRef]
- Munekata, P.E.S.; Yilmaz, B.; Pateiro, M.; Kumar, M.; Domínguez, R.; Shariati, M.A.; Hano, C.; Lorenzo, J.M. Valorization of by-products from Prunus genus fruit processing: Opportunities and applications. Crit. Rev. Food Sci. Nutr. 2022, 63, 7795–7810. [Google Scholar] [CrossRef]
- Rodríguez-Blázquez, S.; Gómez-Mejía, E.; Rosales-Conrado, N.; León-González, M.E.; García-Sánchez, B.; Miranda, R. Valorization of Prunus Seed Oils: Fatty Acids Composition and Oxidative Stability. Molecules 2023, 28, 7045. [Google Scholar] [CrossRef]
- Tsegaye, B.; Jaiswal, S.; Jaiswal, A.K. Food Waste Biorefinery: Pathway towards Circular Bioeconomy. Foods 2021, 10, 1174. [Google Scholar] [CrossRef]
- Mohamed, D.A.; Hamed, I.; Mohammed, S. Utilization of grape and apricot fruits by-products as cheap source for biologically active compounds for health promotion. Egypt. J. Chem. 2021, 64, 2037–2045. [Google Scholar] [CrossRef]
- Quiles, A.; Campbell, G.M.; Struck, S.; Rohm, H.; Hernando, I. Fiber from fruit pomace: A review of applications in cereal-based products. Food Rev. Int. 2018, 34, 162–181. [Google Scholar] [CrossRef]
- Sheikh, M.A.; Saini, C.S.; Sharma, H.K. Antioxidant potential, anti-nutritional factors, volatile compounds and phenolic composition of microwave heat-treated plum (Prunus domestica L.) kernels: An analytical approach. Br. Food J. 2021, 124, 3236–3256. [Google Scholar] [CrossRef]
- Sheikh, M.A.; Saini, C.S.; Sharma, H.K. Computation of design-related engineering properties and fracture resistance of plum (Prunus domestica) kernels to compressive loading. J. Agric. Food Res. 2021, 3, 100101. [Google Scholar] [CrossRef]
- Sheikh, M.A.; Saini, C.S.; Sharma, H.K. Harnessing plum (Prunus domestica L.) processing wastes for the fabrication of bio-composite edible films: An attempt towards a food circular bioeconomy. Food Hydrocoll. 2023, 142, 108790. [Google Scholar] [CrossRef]
- Rudke, C.R.; Zielinski, A.A.; Ferreira, S.R. From biorefinery to food product design: Peach (Prunus persica) by-products deserve attention. Food Bioprocess Technol. 2023, 16, 1197–1215. [Google Scholar] [CrossRef] [PubMed]
- Lara, M.V.; Bonghi, C.; Famiani, F.; Vizzotto, G.; Walker, R.P.; Drincovich, M.F. Stone Fruit as Biofactories of Phytochemicals with Potential Roles in Human Nutrition and Health. Front. Plant Sci. 2020, 11, 562252. [Google Scholar] [CrossRef] [PubMed]
- Fidelis, M.; De Moura, C.; Kabbas, T.; Pap, N.; Mattila, P.; Mäkinen, S.; Putnik, P.; Kovačević, D.B.; Tian, Y.; Yang, B.; et al. Fruit Seeds as Sources of Bioactive Compounds: Sustainable Production of High Value-Added Ingredients from by-Products within Circular Economy. Molecules 2019, 24, 3854. [Google Scholar] [CrossRef]
- Priyadarshi, R.; Sauraj, S.; Kumar, B.; Deeba, F.; Kulshreshtha, A.; Negi, Y.S. Chitosan films incorporated with Apricot (Prunus armeniaca) kernel essential oil as active food packaging material. Food Hydrocoll. 2018, 85, 158–166. [Google Scholar] [CrossRef]
- Wang, D.; Dong, Y.; Chen, X.; Liu, Y.; Wang, J.; Wang, X.; Wang, C.; Song, H. Incorporation of apricot (Prunus armeniaca) kernel essential oil into chitosan films displaying antimicrobial effect against Listeria monocytogenes and improving quality indices of spiced beef. Int. J. Biol. Macromol. 2020, 162, 838–844. [Google Scholar] [CrossRef]
- Ali, A.; Ali, S.; Yu, L.; Liu, H.; Khalid, S.; Hussain, A.; Qayum, M.M.N.; Ying, C. Preparation and characterization of starch-based composite films reinforced by apricot and walnut shells. J. Appl. Polym. Sci. 2019, 136, 47978. [Google Scholar] [CrossRef]
- Farhadi, S.; Javanmard, M. Mechanical and physical properties of polyethylene/sour cherry shell powder bio-composite as potential food packaging. Food Sci. Nutr. 2021, 9, 3071–3077. [Google Scholar] [CrossRef]
- Zhang, C.; Sun, G.; Li, J.; Wang, L. A green strategy for maintaining intelligent response and improving antioxidant properties of κ-carrageenan-based film via cork bark extractive addition. Food Hydrocoll. 2021, 113, 106470. [Google Scholar] [CrossRef]
- Zhang, X.; Liu, Y.; Yong, H.; Qin, Y.; Liu, J.; Liu, J. Development of multifunctional food packaging films based on chitosan, TiO2 nanoparticles and anthocyanin-rich black plum peel extract. Food Hydrocoll. 2019, 94, 80–92. [Google Scholar] [CrossRef]
- Cvetković, K.; Karabegović, I.; Dordevic, S.; Dordevic, D.; Danilović, B. Valorization of Food Industry Waste for Biodegradable Biopolymer-Based Packaging Films. Processes 2025, 13, 2567. [Google Scholar] [CrossRef]
- Li, C.; Pei, J.; Xiong, X.; Xue, F. Encapsulation of grapefruit essential oil in emulsion-based edible film prepared by plum (Pruni domesticae semen) seed protein isolate and gum acacia conjugates. Coatings 2020, 10, 784. [Google Scholar] [CrossRef]
- Pantić, J.; Šuput, D.; Hromiš, N.; Lončar, B.; Popović, S. Sustainable biopolymer films based on plum oil cake: A circular economy approach for food packaging applications. Biomass Convers. Biorefinery 2025, in press. [CrossRef]
- Maravić-Vlahoviček, G.; Kindl, M.; Andričević, K.; Obranić, S.; Vladimir-Knežević, S. Modulatory Effects of Satureja montana L. Essential Oil on Biofilm Formation and Virulence Factors of Pseudomonas aeruginosa. Pharmaceuticals 2025, 18, 1269. [Google Scholar] [CrossRef]
- Maccelli, A.; Vitanza, L.; Imbriano, A.; Fraschetti, C.; Filippi, A.; Goldoni, P. Satureja montana L. Essential oils: Chemical profiles/phytochemical screening, antimicrobial activity and o/w nanoemulsion formulations. Pharmaceutics 2020, 12, 7. [Google Scholar] [CrossRef]
- Novak, U.; Bajić, M.; Kõrge, K.; Oberlintner, A.; Murn, J.; Lokar, K. From waste/residual marine biomass to active biopolymer-based packaging film materials for food industry applications—A review. Phys. Sci. Rev. 2020, 5, 20190099. [Google Scholar] [CrossRef]
- ASTM D882-18; Standard Test Method for Tensile Properties on Thin Plasctic Sheeting. ASTM International: West Conshohocken, PA, USA, 2018.
- ISO 2528:2017; Sheet Materials. Determination of Water Vapor Transmission Rate (WVTR). Gravimetric (Dish) Method. International Organization for Standardization: Geneva, Switzerland, 2017.
- ASTM D5576:00; Standard Practice for Determination of Structural Features in Polyolefins and Polyolefin Copolymers by Infrared Spectrophotometry (FT-IR). ASTM International: West Conshohocken, PA, USA, 2021.
- Šuput, D.; Pezo, L.; Rakita, S.; Spasevski, N.; Tomičić, R.; Hromiš, N. Camelina sativa Oilseed Cake as a Potential Source of Biopolymer Films: A Chemometric Approach to Synthesis, Characterization, and Optimization. Coatings 2024, 14, 95. [Google Scholar] [CrossRef]
- Zahorec, J.; Šoronja-Simović, D.; Kocić-Tanackov, S.; Bulut, S.; Martić, N.; Bijelić, K. Carob Pulp Flour Extract Obtained by a Microwave-Assisted Extraction Technique: A Prospective Antioxidant and Antimicrobial Agent. Separations 2023, 10, 465. [Google Scholar] [CrossRef]
- Akachat, B.; Himed, L.; Salah, M.; D’Elia, M.; Rastrelli, L.; Barkat, M. Development of Pectin-Based Films with Encapsu-lated Lemon Essential Oil for Active Food Packaging: Improved Antioxidant Activity and Biodegradation. Foods 2025, 14, 353. [Google Scholar] [CrossRef]
- Kazak, M.B.; Tugrul, N. Comparison of the Film Properties of Lemon and Sour Cherry Seed Essential Oil-Added Glycerol and/or Sorbitol-Plasticized Corn, Potato, Rice, Tapioca, and Wheat Starch-Based Edible Films. Int. J. Polym. Sci. 2024, 2024, 9112555. [Google Scholar] [CrossRef]
- Sharma, S.; Perera, K.Y.; Mulrey, L.; Duffy, B.; Jaiswal, A.K.; Jaiswal, S. Eucalyptus oil-loaded nanocarriers composite films to enhance the shelf life of cheese. LWT 2025, 219, 117548. [Google Scholar] [CrossRef]
- Khalili, E.; Jahed Khaniki, G.; Shojaee-Aliabadi, S.; Shariatifar, N.; Aslani, R.; Mirmoghtadaie, L. Development and characterization of amaranth protein-based edible films incorporating Satureja khuzestanica essential oil. Appl. Food Res. 2025, 5, 100967. [Google Scholar] [CrossRef]
- Bulut, S.; Popović, S.; Hromiš, N.; Šuput, D.; Adamović, D.; Lazić, V. Incorporation of essential oils into pumpkin oil cake-based materials in order to improve their properties and reduce water sensitivity. Hem. Ind. 2020, 74, 313–325. [Google Scholar] [CrossRef]
- Šuput, D.; Lončar, B.; Hromiš, N.; Popović, S.; Rakita, S.; Spasevski, N. The influence of essential oils on the properties of biopolymer films based on wild flax (Camelina sativa L.). J. Reprocess Energy Agric. 2024, 28, 7–11. [Google Scholar] [CrossRef]
- Petraru, A.; Amariei, S. A Novel Approach about Edible Packaging Materials Based on Oilcakes—A Review. Polymers 2023, 15, 3431. [Google Scholar] [CrossRef]
- Li, Y.; Xin, R.; Wang, S.; Guo, Z.; Sun, X.; Ren, Z. Structure and Mechanical Property of Melt-Drawn Oriented PLA Ultrathin Films. Macromolecules 2021, 54, 9124–9134. [Google Scholar] [CrossRef]
- Le, T.H.; Dinh, D.A.; Le, M.T.; Le, T.; Van Bui, V.T. Enhancing water resistance and mechanical properties of starch-based edible biofilms through chitosan, seaweed, and sodium tripolyphosphate modifications. Polym. Eng. Sci. 2024, 64, 5176–5185. [Google Scholar] [CrossRef]
- Silva, S.P.M.; Teixeira, J.A.; Silva, C.C.G. Recent advances in the use of edible films and coatings with probiotic and bacteriocin-producing lactic acid bacteria. Food Biosci. 2023, 56, 103196. [Google Scholar] [CrossRef]
- Zhang, R.; Zhai, X.; Wang, W.; Hou, H. Preparation and evaluation of agar/maltodextrin-beeswax emulsion films with various hydrophilic-lipophilic balance emulsifiers. Food Chem. 2022, 384, 132541. [Google Scholar] [CrossRef]
- Khan, S.; Abdo, A.A.A.; Shu, Y.; Zhang, Z.; Liang, T. The Extraction and Impact of Essential Oils on Bioactive Films and Food Preservation, with Emphasis on Antioxidant and Antibacterial Activities—A Review. Foods 2023, 12, 4169. [Google Scholar] [CrossRef]
- Devi, L.S.; Jaiswal, A.K.; Jaiswal, S. Lipid incorporated biopolymer based edible films and coatings in food packaging: A review. Curr. Res. Food Sci. 2024, 8, 100720. [Google Scholar] [CrossRef]
- Zhang, R.; Wang, W.; Zhang, H.; Dai, Y.; Dong, H.; Hou, H. Effects of hydrophobic agents on the physicochemical properties of edible agar/maltodextrin films. Food Hydrocoll. 2019, 88, 283–290. [Google Scholar] [CrossRef]
- Alves, L.T.O.; Fronza, P.; Gonçalves, I.; da Silva, W.A.; Oliveira, L.S.; Franca, A.S. Development of Polymeric Films Based on Sunflower Seed Proteins and Locust Bean Gum. Polymers 2024, 16, 1905. [Google Scholar] [CrossRef]
- Cano-Trujillo, C.; García-Ruiz, C.; Ortega-Ojeda, F.E.; Montalvo, G. Differentiation of blood and environmental interfering stains on substrates by Chemometrics-Assisted ATR FTIR spectroscopy. Spectrochim. Acta A Mol. Biomol. Spectrosc. 2023, 292, 122409. [Google Scholar] [CrossRef]
- Valderrama, A.C.S.; Rojas De, G.C. Traceability of Active Compounds of Essential Oils in Antimicrobial Food Packaging Using a Chemometric Method by ATR-FTIR. Am. J. Anal. Chem. 2017, 8, 726–741. [Google Scholar] [CrossRef]
- Agnieszka, N.; Danuta, K.; Malgorzata, P.; Agata, C. Effects of thyme (Thymus vulgaris L.) and rosemary (Rosmarinus officinalis L.) essential oils on growth of Brochothrix thermosphacta. Afr. J. Microbiol. Res. 2013, 7, 3396–3404. [Google Scholar] [CrossRef]
- Bulut, H.; Tarhan, N.; Büyük, M.; Serin, K.R.; Ulukaya, E.; Depciuch, J. Assessment of Oxidative Stress Effects in Serum Determined by FT-IR Spectroscopy in Cholangiocarcinoma Patients. Biointerface Res. Appl. Chem. 2023, 13, 151. [Google Scholar] [CrossRef]
- Agatonovic-Kustrin, S.; Ristivojevic, P.; Gegechkori, V.; Litvinova, T.M.; Morton, D.W. Essential oil quality and purity evaluation via ft-ir spectroscopy and pattern recognition techniques. Appl. Sci. 2020, 10, 7294. [Google Scholar] [CrossRef]
- Asghar, L.; Sahar, A.; Khan, M.I.; Shahid, M. Fabrication and Characterization of Chitosan and Gelatin-Based Antimicrobial Films Incorporated with Different Essential Oils. Foods 2024, 13, 1796. [Google Scholar] [CrossRef]
- Pommet, M.; Redl, A.; Guilbert, S.; Morel, M.H. Intrinsic influence of various plasticizers on functional properties and reactivity of wheat gluten thermoplastic materials. J. Cereal Sci. 2005, 42, 81–91. [Google Scholar] [CrossRef]
- de Oliveira e Silva Guerrero, A.; da Silva, T.N.; Cardoso, S.A.; da Silva, F.F.F.; de Carvalho Patricio, B.F.; Gonçalves, R.P. Chitosan-based films filled with nanoencapsulated essential oil: Physical-chemical characterization and enhanced wound healing activity. Int. J. Biol. Macromol. 2024, 261, 129049. [Google Scholar] [CrossRef] [PubMed]
- Bhatia, S.; Abbas Shah, Y.; Al-Harrasi, A.; Jawad, M.; Koca, E.; Aydemir, L.Y. Enhancing Tensile Strength, Thermal Stability, and Antioxidant Characteristics of Transparent Kappa Carrageenan Films Using Grapefruit Essential Oil for Food Packaging Applications. ACS Omega 2024, 9, 9003–9012. [Google Scholar] [CrossRef]
- Di Matteo, A.; Stanzione, M.; Orlo, E.; Russo, C.; Lavorgna, M.; Buonocore, G.G. Biodegradable films enriched with thymol and carvacrol with antioxidant and antibacterial properties to extend cheese shelf-life. Food Control 2026, 179, 111541. [Google Scholar] [CrossRef]
- Mariño-Cortegoso, S.; Stanzione, M.; Andrade, M.A.; Restuccia, C.; Rodríguez-Bernaldo de Quirós, A.; Buonocore, G.G. Development of active films utilizing antioxidant compounds obtained from tomato and lemon by-products for use in food packaging. Food Control 2022, 140, 109128. [Google Scholar] [CrossRef]
- Šuput, D.; Lazić, V.; Pezo, L.; Markov, S.; Vaštag, Ž.; Popović, L. Characterization of starch edible films with different essential oils addition. Pol. J. Food Nutr. Sci. 2016, 66, 277–285. [Google Scholar] [CrossRef]
- Ponce, A.G.; Fritz, R.; Del Valle, C.; Roura, S.I. Antimicrobial activity of essential oils on the native microflora of organic Swiss chard. LWT 2003, 36, 679–684. [Google Scholar] [CrossRef]
- Saxena, D.; Maitra, R.; Bormon, R.; Czekanska, M.; Meiers, J.; Titz, A. Tackling the outer membrane: Facilitating compound entry into Gram-negative bacterial pathogens. npj Antimicrob. Resist. 2023, 1, 17. [Google Scholar] [CrossRef]
- Fratini, F.; Casella, S.; Leonardi, M.; Pisseri, F.; Ebani, V.V.; Pistelli, L. Antibacterial activity of essential oils, their blends and mixtures of their main constituents against some strains supporting livestock mastitis. Fitoterapia 2014, 96, 1–7. [Google Scholar] [CrossRef]
- Ćavar, S.; Maksimović, M.; Šolić, M.E.; Jerković-Mujkić, A.; Bešta, R. Chemical composition and antioxidant and antimicrobial activity of two Satureja essential oils. Food Chem. 2008, 111, 648–653. [Google Scholar] [CrossRef]
- Bulut, S.; Popović, S.; Hromiš, N.; Šuput, D.; Lazić, V.; Kocić-Tanackov, S.; Dimić, G.; Kravić, S. Antibacterial activity of biopolymer composite materials obtained from pumpkin oil cake and winter savory or basil essential oil against various pathogenic bacteria. J. Food Nutr. Res. 2020, 59, 250–258. [Google Scholar]
- Yuan, Y.; Hui, X.; Liu, Z.; Sun, J.; Raka, R.N.; Xiao, J. Investigation of differential Multi-Mode antibacterial mecha-nisms of essential oils of Satureja montana L. and Leptospermum scoparium J.R.Forst. & G.Forst. Against Porphyromonas gingivalis. BMC Complement. Med. Ther. 2025, 25, 283. [Google Scholar] [CrossRef]
- García-Díaz, M.; Gil-Serna, J.; Patiño, B.; García-Cela, E.; Magan, N.; Medina, Á. Assessment of the effect of satureja montana and origanum virens essential oils on aspergillus flavus growth and aflatoxin production at different water activities. Toxins 2020, 12, 142. [Google Scholar] [CrossRef]
- Said-Al Ahl, H.A.H.; Kačániova, M.; Mahmoud, A.A.; Hikal, W.M.; Čmiková, N.; Szczepanek, M. Phytochemical Characterization and Biological Activities of Essential Oil from Satureja montana L., a Medicinal Plant Grown un-der the Influence of Fertilization and Planting Dates. Biology 2024, 13, 328. [Google Scholar] [CrossRef]
- Dodoš, T.; Jankovi, S.; Marin, P.D.; Rajčevi, N. Essential Oil Composition and Micromorphological Traits of Satureja montana L.; S. subspicata Bartel Ex Vis., and S. kitaibelii Wierzb. Ex. Heuff. Plant Organs. Plants 2021, 10, 511. [Google Scholar] [CrossRef]
- Abdelshafeek, K.A.; Osman, A.F.; Mouneir, S.M.; Elhenawy, A.A.; Abdallah, W.E. Phytochemical profile, comparative evaluation of Satureja montana alcoholic extract for antioxidants, anti-inflammatory and molecular docking studies. BMC Complement. Med. Ther. 2023, 23, 108. [Google Scholar] [CrossRef]
- Bulut, S.; Popović, S.; Hromiš, N.; Šuput, D.; Malbaša, R.; Vitas, J.; Lazić, V. Incorporation of essential oils into biopolymer films based on pumpkin oil cake in order to improve their antioxidant activity. Chem. Ind. 2019, 23, 162–166. [Google Scholar] [CrossRef]

| Sample | Thickness (mm) | Moisture Content (%) | Solubility (%) | Swelling Degree (%) | WVTR (g m−2 h−1) | WVP (g m−1 s−1 Pa−1) × 10−13 |
|---|---|---|---|---|---|---|
| C | 0.145 ± 0.003 a | 9.47 ± 0.69 c | 43.46 ± 0.61 b | 86.82 ± 3.01 b | 4.88 ± 0.14 a | 6.76 ± 0.21 a |
| 1% SMeo | 0.183 ± 0.002 a | 15.46 ± 1.55 bc | 14.12 ± 1.09 ab | 73.89 ± 0.47 a | 4.24 ± 0.50 a | 6.52 ± 0.26 a |
| 2% SMeo | 0.202 ± 0.033 a | 14.23 ± 1.25 ab | 11.66 ± 0.51 a | 60.51 ± 0.76 c | 3.95 ± 0.19 a | 6.25 ± 0.15 a |
| 3% SMeo | 0.221 ± 0.023 a | 10.57 ± 0.77 ab | 10.10 ± 0.59 c | 57.20 ± 1.14 c | 2.85 ± 0.24 b | 3.56 ± 0.20 b |
| Sample | Low-T Endotherm (Melting/Denaturation) (°C) | Enthalpy ΔH (J/g) | High-T Endotherm (Melting/Denaturation) (°C) | Enthalpy ΔH (J/g) | Decomposition Temperature (°C) |
|---|---|---|---|---|---|
| C | 133.07 | 148.1 | 191.21 | 0.93 | 229.3 |
| 1% SMeo | 134.02 | 1.5 | 171.58 | 166.1 | 220.24 |
| 2% SMeo | 131.93 | 0.9 | 160.24 | 17.12 | 212.3 |
| 3% SMeo | 128.52 | 118.0 | 194.9 | 2.1 | 213.9 |
| Sample | Antimicrobial Activity of Biofilms (mm) | ||||||
|---|---|---|---|---|---|---|---|
| E. coli | S. aureus | B. cereus | C. albicans | A. flavus | A. parasiticus | A. ochraceus | |
| C | ND | ND | ND | ND | ND | ND | ND |
| 1% SMeo | 11.0 ± 1.4 a | 17.5 ± 3.5 a | 13.5 ± 2.1 a | 16.5 ± 2.1 a | 8.0 ± 0.0 a | 9.5 ± 0.7 a | 10.0 ± 0.0 a |
| 2% SMeo | 12.5 ± 1.4 a | 31.75 ± 2.5 a | 15.5 ± 4.9 a | 20.5 ± 4.9 a | 9.0 ± 0.0 a | 10.5 ± 0.7 a | 21.0 ± 0.0 a |
| 3% SMeo | 23.5 ± 0.7 b | 45.0 ± 1.4 b | 30.5 ± 2.5 b | 38.0 ± 1.4 b | 13.5 ± 1.4 b | 19.0 ± 4.2 a | 42.5 ± 3.5 a |
Disclaimer/Publisher’s Note: The statements, opinions and data contained in all publications are solely those of the individual author(s) and contributor(s) and not of MDPI and/or the editor(s). MDPI and/or the editor(s) disclaim responsibility for any injury to people or property resulting from any ideas, methods, instructions or products referred to in the content. |
© 2025 by the authors. Licensee MDPI, Basel, Switzerland. This article is an open access article distributed under the terms and conditions of the Creative Commons Attribution (CC BY) license (https://creativecommons.org/licenses/by/4.0/).
Share and Cite
Pantić, J.; Šuput, D.; Kocić-Tanackov, S.; Bulut, S.; Ristić, I.; Lončar, B.; Hromiš, N.; Popović, S. Can Satureja montana Essential Oil Promote Edible Films Based on Plum Oil Cake into Antimicrobial and Antioxidant Food Packaging? Coatings 2025, 15, 1327. https://doi.org/10.3390/coatings15111327
Pantić J, Šuput D, Kocić-Tanackov S, Bulut S, Ristić I, Lončar B, Hromiš N, Popović S. Can Satureja montana Essential Oil Promote Edible Films Based on Plum Oil Cake into Antimicrobial and Antioxidant Food Packaging? Coatings. 2025; 15(11):1327. https://doi.org/10.3390/coatings15111327
Chicago/Turabian StylePantić, Jovana, Danijela Šuput, Sunčica Kocić-Tanackov, Sandra Bulut, Ivan Ristić, Biljana Lončar, Nevena Hromiš, and Senka Popović. 2025. "Can Satureja montana Essential Oil Promote Edible Films Based on Plum Oil Cake into Antimicrobial and Antioxidant Food Packaging?" Coatings 15, no. 11: 1327. https://doi.org/10.3390/coatings15111327
APA StylePantić, J., Šuput, D., Kocić-Tanackov, S., Bulut, S., Ristić, I., Lončar, B., Hromiš, N., & Popović, S. (2025). Can Satureja montana Essential Oil Promote Edible Films Based on Plum Oil Cake into Antimicrobial and Antioxidant Food Packaging? Coatings, 15(11), 1327. https://doi.org/10.3390/coatings15111327










